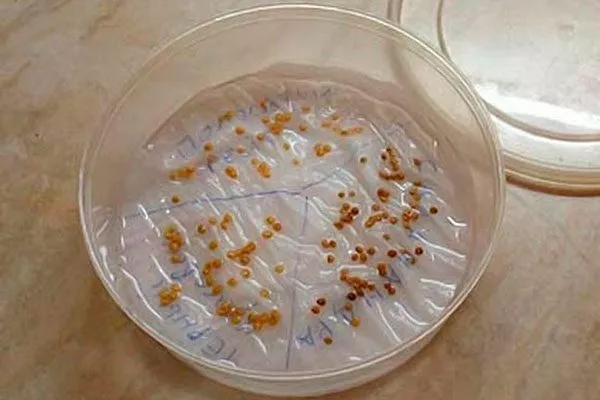
Подготовка семян

Томат Золотая канарейка F1 — гибридный сорт с жёлтовато-оранжевыми плодами, собранными в крупные кисти. Этот сорт отличается высокой урожайностью и подходит для выращивания в любом типе грунта.
История создания сорта Золотая канарейка
Гибридный томат Золотая канарейка выведен российским селекционерами В.И. Блокин-Мечталиным и К.К. Куликовым. К выращиванию этот гибрид допущен в 2019 году. Рекомендован для использования во всех регионах России.
На рынке также присутствует сорт с одноименным названием, из-за чего может возникнуть путаница. От гибрида Золотая канарейка он отличается, прежде всего, плодами. У сорта Золотая канарейка (Akmore Treasure) плоды не круглые, а вытянутые, похожи на сливки. Цвет у них ярко-жёлтый, а носик длинный и острый.
Описание растения и плодов
Кусты высокорослые, размером до 2 м, относятся к индетерминантному типу растений. Листья средней величины, зелёные. Соцветия простые, первое закладывается над 7-8 листом, а все следующие — через 2-3 листа.
Плоды у томата Золотая Канарейка F1 среднего размера, толстостенные, с семенными камерами среднего размера. Некрупные помидорки собраны в кисти — на каждой по 30 штук. Плодоножки — с сочленением.
Краткое описание плодов:
- Цвет незрелого плода: светло-зелёный.
- Цвет зрелого плода: золотисто-оранжевый.
- Форма: округлые, слаборебристые, с небольшим «носиком».
- Вес: 100-130 г.
Вкус и назначение
Мякоть у плодов томата Золотая канарейка по консистенции напоминает киви. Вкус у неё сладкий с приятной кислинкой. Плоды универсальные, они идеально подходят для употребления в свежем виде и цельноплодного консервирования.
Золотистые помидоры также можно использовать для приготовления салатов, соков, различных блюд и других заготовок. Плоды этого сорта имеют практически десертный вкус, кроме того, они подойдут для людей с аллергической реакцией на красные томаты.
Характеристики
Томат Золотая канарейка относится к сортам с ранними сроками созревания. От момента появления всходов до созревания первых плодов проходит 95-100 дней.
Урожайность гибрида составляет около 16 кг/кв. м. С куста собирают 4-7 кг помидоров. Гибрид показывает повышенную устойчивость к альтернариозу, вертициллезу и фузариозному увяданию.
Плюсы и минусы
Томат Золотая канарейка обладает множеством достоинств, ценных для огородников и любителей помидоров. Но, прежде чем высадить этот гибрид на своём огороде, полезно ознакомиться со всеми его преимуществами и недостатками.
Особенности посадки
Гибрид Золотая канарейка можно растить в открытом грунте и в плёночных теплицах. При выращивании этого томата используется рассадный метод.
Выбор участка
Гибрид Золотая канарейка выращивают на хорошо освещённых участках, солнце должно падать на кусты в течение всего дня, затенения быть не должно. Даже небольшое затенение может спровоцировать развитие грибковых заболеваний.
Если высадка производится в открытый грунт, особенно важно, чтобы на участке не было сквозняков. Желательно также наличие препятствия с северной стороны — это убережёт помидорные кусты от воздействия порывистых, холодных ветров. Но циркуляция воздуха на участке быть должна, её отсутствие приводит к развитию грибковых заболеваний.
Томатам не подходят низины, заболачиваемые и подтапливаемые участки, им также противопоказаны места с высоким залеганием грунтовых вод. Не годятся также места, на которых росли паслёновые культуры — томаты, картофель, перец, баклажаны, лучшие предшественники — капуста. Лук, чеснок, тыквенные и бобовые культуры.
Подготовка почвы
Для томатов нужна хорошо дренированная почва, рыхлая и плодородная, с рН от 6,0 до 7,0. Участок осенью очищают от растительных остатков и перекапывают, внося под перекопку органику — перегной или компост (по 10 л на 1 кв. м).
Если грунт имеет повышенную кислотность, необходимо внести в него раскисляющие вещества — например, гашёную известь (500 г на 1 кв. м). Почву также рекомендуется обеззаразить, внося в нее фунгицидные биопрепараты, например, Фитоспорин.
Подготовка семян
Томат Золотая Канарейка является гибридом, поэтому семена необходимо покупать, самосбор для посадки не годится. Посадочный материал обычно полностью готов к посадке, откалиброван, продезинфицирован и обработан стимуляторами, остаётся его только прорастить.
Семена выкладывают на влажную марлю, заворачивают их в неё, и оставляют на 1-2 дня — пока не проклюнутся ростки.
Выращивание рассады
Рассаду можно купить или вырастить самостоятельно. Второй вариант более надёжный, он позволяет получить к нужному сроку здоровые саженцы, обладающие сортовыми признаками.
Особенности выращивания рассады томата Золотая Канарейка:
- Под посадку используйте контейнеры, кассеты или другую тару с дренажными отверстиями — для отвода излишков воды. Сеять томаты можно в общую и индивидуальную тару. Но, в первом случае обязательной является пикировка, при которой сеянцы рассаживают в отдельные горшки или стаканы ёмкостью 350-500 мл.
- Если предполагается использовать пустую тару, а не торфяные горшки, необходимо купить питательный грунт или приготовить его самостоятельно, например, смешав песок, торф и перегной, взятые в равных частях.
- Горшки наполняют субстратом на 2/3, увлажняют его, разравнивают и производят высев семян. В индивидуальную тару высаживают не по одному семечку, а по 2-3, чтобы гарантировано получить всходы и выбрать наиболее крепкий и здоровый росток.
- В контейнеры семена высевают рядами, соблюдая между ними интервалы в 4 см, а между соседними семечками — 2-3 см.
- Посевы прикрывают полиэтиленовой плёнкой и держат в тёплом помещении, но не у окна. Туда их перемещают только после появления всходов. Мини-парник ежедневно открывают, чтобы проветривать и при необходимости увлажнить посевы.
Как правильно ухаживать за рассадой?
Во время выращивания рассады крайне важно соблюдать температурный режим. Необходимо вовремя понижать и повышать температуру — до появления всходов в помещении её поддерживают на уровне +25..+28 °C, а как только взойдут томаты, её понижают до +14..+16 °C. Такое похолодание позволяет предотвратить вытягивание сеянцев.
Особенности ухода за рассадой:
- Через 5-7 суток «холодного режима» температуру повышают до +22…+25 °C. Ночные температуры должны быть на 4-5 градусов ниже.
- Сразу после появления всходов рассаде томатов требуется круглосуточное освещение. Через пару недель длина светового дня сокращается до 18-20 часов, ещё через полмесяца роста — до 11-12 часов.
- Поливают рассаду аккуратно, стараясь не допускать опадания брызг на сеянцы — вода может спровоцировать грибковые заболевания. Для поливов используют только тёплую отстоянную воду.
- До пикировки частота поливов невысокая — 1 раз в неделю, после — 2-3 раза в неделю. Также после пикировки (через 2 недели) начинают вносить подкормки — комплексные минеральные составы. Достаточно 2-3 подкормок.
- Пикируют сеянцы в двухнедельном возрасте. При пересадке растениям прищипывают центральный корень — на 1/3 длины. Оптимальная влажность воздуха для выращивания помидорной рассады — 60-70%.
- За 2 недели до пересадки саженцев в грунт начинают их закалку. Рассаду выносят на улицу, чтобы приучить её к новой среде. Постепенно время пребывания на свежем воздухе увеличивают.
Высадка рассады
В открытый грунт томаты высаживают только после того, как будет исключена угроза заморозков, в большинстве регионов России этот период приводится на конец мая-начало июня, на юге высадку производят на пару недель раньше. В закрытый грунт рассаду томатов высаживают в апреле-мае, в зависимости от климатических особенностей в регионе.
Особенности высадки рассады томата Золотая Канарейка:
- Под посадку копают лунки — рядами или в шахматном порядке. Глубина лунок должна составлять примерно 15-20 см.
- В лунки насыпают удобрения — пару горстей перегноя или компоста и 1-2 ст. л. древесной золы. Также огородники часто кладут в лунки луковую шелуху или яичную скорлупу. А вот свежий навоз противопоказан — он может «сжечь» корни.
- Удобрения перемешивают с землёй и заливают 1 л тёплой воды. Через час, когда грунт немного осядет, высаживают саженцы, углубляя их до первых листочков. Если рассада вытянулась, её сажают под наклоном, углубляя часть стебля. Макушки растений должны смотреть на север.
- Рассаду важно предварительно полить, тогда её можно легко извлечь из посадочных емкостей.
- Корни саженцев засыпают почвой, аккуратно трамбуют, формируя вокруг стебля углубление — для удобства полива. В теплицах рекомендуется проложить шланги для капельного орошения, да и в открытом грунте такая система позволит упростить полив культуры.
- Приствольную зону, когда вода впитается, мульчируют соломой, скошенной травой, торфом и т.п.
Рекомендуемая схема посадки томата Золотая Канарейка: 25-30 см х 50-65 см. На 1 кв. м высаживают не более 4-х растений.
Особенности ухода
Гибрид Золотая Канарейка довольно требователен к уходу, но ничего сверх стандартных агротехнических мероприятий ему не требуется. Кусты важно вовремя поливать, рыхлить и подкармливать, опрыскивать в лечебных и профилактических целях, выполнять другие действия, направленные на обеспечение роста и развития кустов, их обильного плодоношения.
Полив
Поливы томату Золотая Канарейка нужны редкие, но обильные. Воду льют под корень, дождевание не требуется. Первый раз рассаду поливают через 10 дней после высадки — отсутствие влаги вынуждает растение искать воду, благодаря чему происходит интенсивное разрастание корней — это способствует укоренению. Растений.
Потребность в воде у помидорных кустов особенно возрастает в период формирования завязей. Под каждое растений льют не менее 10 л воды. Чтобы замедлить испарение влаги, почву мульчируют. Во время плодоношения поливы сокращают.
Рыхление
Чтобы почва насыщалась кислородом, её необходимо регулярно рыхлить. Лучше всего это делать на следующий день после полива. Сначала грунт рыхлят на глубину 10 см, позднее, когда у кустов разовьются корни, рыхление становится менее глубоким — 3-4 см.
Через 2-3 недели после высадки рассаду окучивают. За сезон помидорные кусты нужно окучить ещё 2 раза. Одновременно под кусты можно вносить минеральные удобрения.
Подкормки
Урожайность сорта во многом зависит от питательности грунта, поэтому ему требуются регулярные подкормки. Во время посадки саженцев можно внести Борофоску, которая благотворно влияет иммунную систему растений, на развитие их корневой системы, а также на рост и плодоношение.
Сразу после посадки вносят минеральные составы, которые быстро усваиваются корнями. Также рекомендуется мульчировать почву органикой, например, соломой или опилками. В период цветения вносят калий, который повышает качество цветков и завязывания плодов, а также фосфор — для стимулирования развития корневой системы.
На этапе плодоношения вносят комплексные калийно-фосфорные удобрения с добавлением кальция, который предотвращает появление вершинной гнили и улучшает структуру плодов. Для подкормки помидорных кустов используют также мочевину, сульфат магния, селитру, монофосфат калия и другие удобрения.
Формирование и подвязка
Томат Золотая Канарейка нуждается в подвязке, пасынковании и формировании. При выращивании в невысоких теплицах кусты формируют в 2 стебля, если высадка произведена в высокие (более 2 м) сооружения — в 1 стебель. В последнем случае, плоды вырастают более крупными.
Болезни и вредители
Томат Золотая Канарейка довольно устойчив к альтернариозу и фузариозному увяданию, но при неблагоприятных обстоятельствах может поражаться заболеваниями грибковой или бактериальной природы.
В начале сезона кусты рекомендуется опрыскивать для профилактики Фитоспорином-М и медным купоросом, в середине лета применяют также медьсодержащие препараты, например 1%-ный раствор бордоской жидкости, ОксиХОМ и другие
Наиболее часто томат Золотая канарейка поражается тлёй, трипсами, белокрылкой. Для обработки помидорных кустов от вредителей можно применять как народные средства (настой чеснока, мыльный раствор и т.п.), так и биопрепараты — Фитоверм, Актовит и т. п.
Сбор и хранение урожая
Урожай с томата Золотая Канарейка собирают в июле. Лучшее время для сбора плодов — раннее утро, до наступления жары. Снимают помидоры немного недозревшими, когда появится лёгкий румянец. Плоды укладывают в картонные коробки в один слой. Дозревание при комнатной температуре происходит в течение 5-6 дней.
На хранение закладывают только целые плоды, без повреждений, вмятин, трещин и прочих дефектов. При температуре +15 °C помидоры гибрида Золотая Канарейка могут лежать примерно 7-8 суток.
Отзывы
Томат Золота Канарейка — отличный выбор для тех, кто ищет универсальные и урожайные помидоры. Этот замечательный гибрид удачно сочетает в себе прекрасный вкус плодов, которые годятся для любых целей — от приготовления салатов до консервирования целиком.